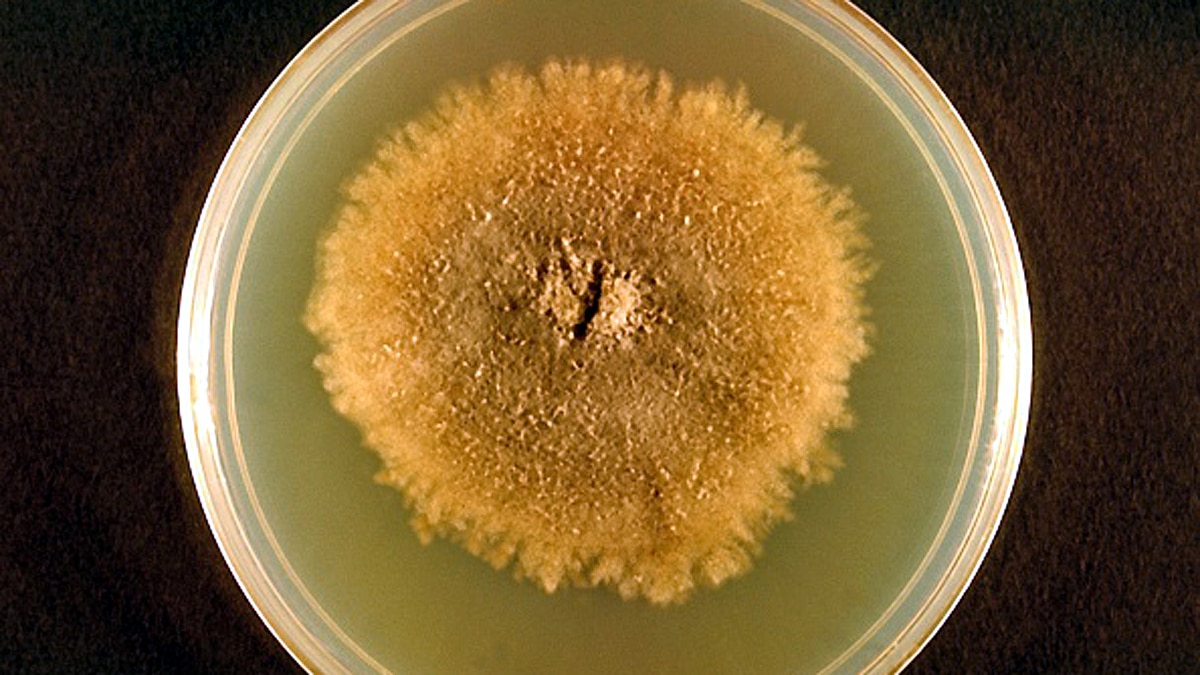
Mysterious brain invading fungus
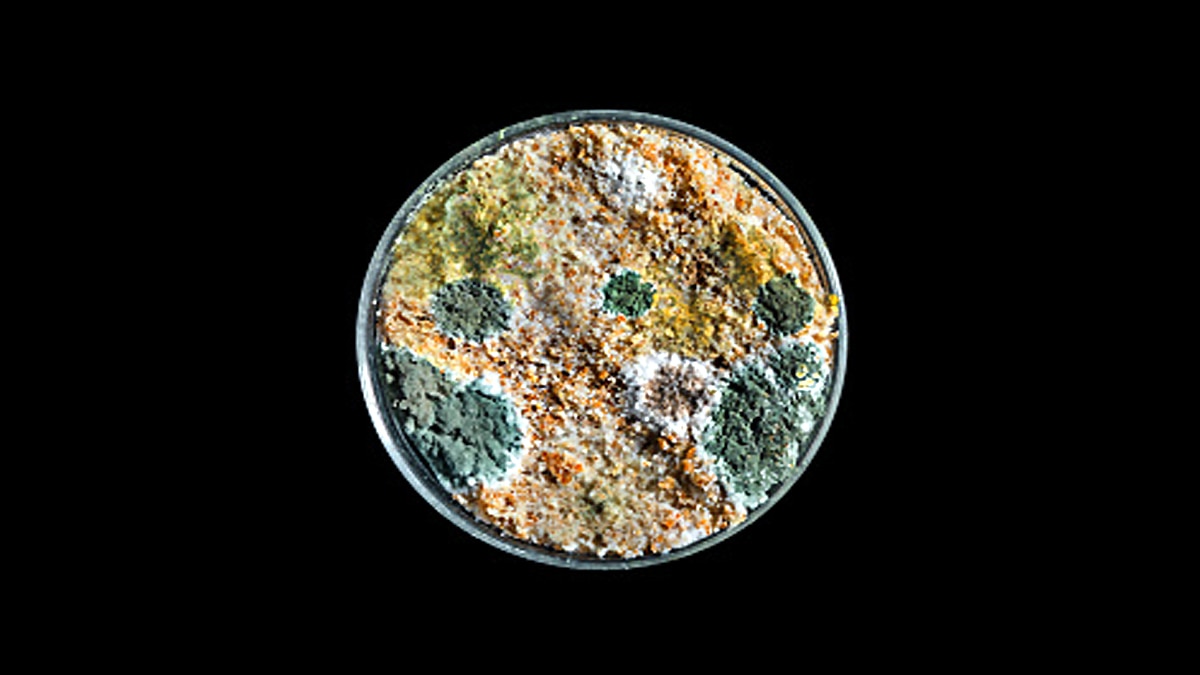
Mysterious brain invading fungus

जमीन से समुद्र में पहुंचा 'दिमाग खाने वाला' फंगस, इंसान से लेकर डॉल्फिन तक शिकार
दिमाग को बुरी तरह प्रभावित करके जान लेने वाला एक फंगस जमीन से समुद्र में पहुंच गया. जिसकी वजह से 40 डॉल्फिन्स और पॉरपॉएज (Porpoises) की मौत हो चुकी है. ये फंगस प्रशांत महासागर के उत्तर-पश्चिम में तेजी से फैल रहा है. 1997 से 2016 के बीच वैज्ञानिकों को 42 ऐसी मरी हुई डॉल्फिन्स मिलीं, जो फंगस की वजह से मारी गईं. (फोटोः गेटी)
वैज्ञानिकों को वॉशिंगटन और ब्रिटिश कोलंबिया के आसपास सैलिश सागर (Salish Sea) में ये 42 डॉल्फिन्स मरी मिली थीं. इनके शरीर में जो फंगस था, वह जमीन पर पाया जाता है. मिट्टी में या फिर पेड़ों पर. उसके समुद्र में जाने का रहस्य अब सुलझा है. इस फंगस का नाम है क्रिप्टोकोकस गट्टी (Cryptococcus gattii). यह उष्णकटिबंधीय फंगस (Tropical Fungus) है, जिसने डॉल्फिन्स के फेफड़ों और दिमाग को बुरी तरह से प्रभावित किया था. ये दिमाग के फैसले लेने की क्षमता खत्म करता है, उसके बाद उसे अंदर ही अंदर खा जाता है. (फोटोः गेटी)
ब्रिटिश कोलंबिया में इसी क्रिप्टोकोकस गट्टी (Cryptococcus gattii) फंगस की वजह से 1999 से 2007 के बीच 218 लोग बीमार पड़े. जिनमें से 19 लोगों की मौत हो गई. लेकिन ये रहस्य तब से बरकरार था कि ये समुद्र से जमीन पर आया या जमीन से समुद्र में गया क्योंकि ये आमतौर पर जमीन पर मिट्टी के अंदर रहता है. फिर ये समुद्री जीवों को कैसे प्रभावित कर रहा है. यह एक जीव से दूसरे में जाता भी नहीं है. इसलिए वैज्ञानिक परेशान होते रहे. खैर...अब इस रहस्य का खुलासा हो गया है. (फोटोः गेटी)
हाल ही में डिजीसेस ऑफ एक्वेटिक ऑर्गेनिज्म नाम के जर्नल में छपी एक रिपोर्ट के मुताबिक क्रिप्टोकोकस गट्टी (Cryptococcus gattii) क्लाइमेट चेंज की वजह से इस फंगस के रहने का स्थान बदल रहा है. यह ट्रॉपिकल इलाके को छोड़कर उत्तर की ओर जा रहा है. जंगलों की कटाई और लगातार बन रहे शहरों से फंगस जमीनों और पेड़ों से निकल कर हवा में तैरते हुए समुद्र तक पहुंच गया. (फोटोः गेटी)
उसके बाद यह समुद्र की ऊपरी सतह पर तैरता रहा. जिसे डॉल्फिन्स और पॉरपॉएज मछलियों ने सांस लेते समय शरीर में ले लिया. क्योंकि ये दोनों मछलियां गहरे पानी में तो रहती ही है, लेकिन हवा में उछाल मारने और ऑक्सीजन लेने के लिए बीच-बीच में समुद्र के ऊपरी सतह की ओर भी आती हैं. अक्सर लहरों के साथ खेलती हैं. इंसानों की बोट्स और नावों के आगे-पीछे चक्कर लगाती हैं. इस वजह से इनके सांस लेने के समय इस फंगस के छोटे-छोटे कण शरीर में चले गए होंगे. (फोटोः गेटी)
सैलिश सागर में मिला क्रिप्टोकोकस गट्टी (Cryptococcus gattii) का पहला केस 1997 में सामने आया था. तब कई डॉल्फिन्स और पॉरपॉएज मछलियां मारी गई थीं. इसके दो साल बाद 1999 में इंसानों में इस फंगस का संक्रमण फैला. वैज्ञानिक अभी ये समझने की कोशिश कर रहे हैं कि जमीन से समुद्र में जाकर मछलियों को मारने वाला फंगस इंसानों को कैसे संक्रमित कर रहा है. (फोटोः गेटी)
यह सिर्फ एक उदाहरण कि कैसे क्लाइमेट चेंज की वजह से जमीन के फंगस ने अपना इलाका बढ़ा लिया. कैलिफोर्निया के दक्षिण-पश्चिम इलाकों में कोकीडियोडेस फंगस का संक्रमण 2014 से 2018 के बीच तीन गुना बढ़ गया है. इसे वैली फीवर (Valley Fever) भी कहते हैं. साल 2019 में हुई एक मॉडलिंग स्टडी के मुताबिक साल 2100 तक यह बीमारी अपना इलाका बढ़ाकर कंसास या उत्तरी डकोटा तक कर सकती है. (फोटोः गेटी)
साल 2019 में mBio में आई एक स्टडी के मुताबिक ड्रग रेजिसटेंट फंगस कैंडिडा ऑरिस (Candida Auris) एशिया, यूरोप और अमेरिका में कई बार संक्रमण फैला चुका है. इसका पहला संक्रमण साल 2009 में टोक्यो की एक महिला में देखने को मिला था. इस फंगस ने इंसानी शरीर में प्रवेश करने के लिए बढ़ते तापमान और ग्लोबल वॉर्मिंग का सहारा लिया. खुद को अधिक तापमान में रहने लायक बनाया. (फोटोः गेटी)
यूनिवर्सिटी ऑफ कैलिफोर्निया की शोधकर्ता सारा टेमैन ने कहा कि जिस तरह से पर्यावरण में बदलाव हो रहे हैं, उससे कई आपदाएं तो आएंगी ही, लेकिन सबसे ज्यादा खतरा है बीमारियों का. न जाने किस जगह से कौन सा फंगस, वायरस या बैक्टीरिया इंसानों और जानवरों पर हमला करने लगे. हम इंसान ऐसी बीमारियों को लिए तैयार नहीं हैं. (फोटोः गेटी)